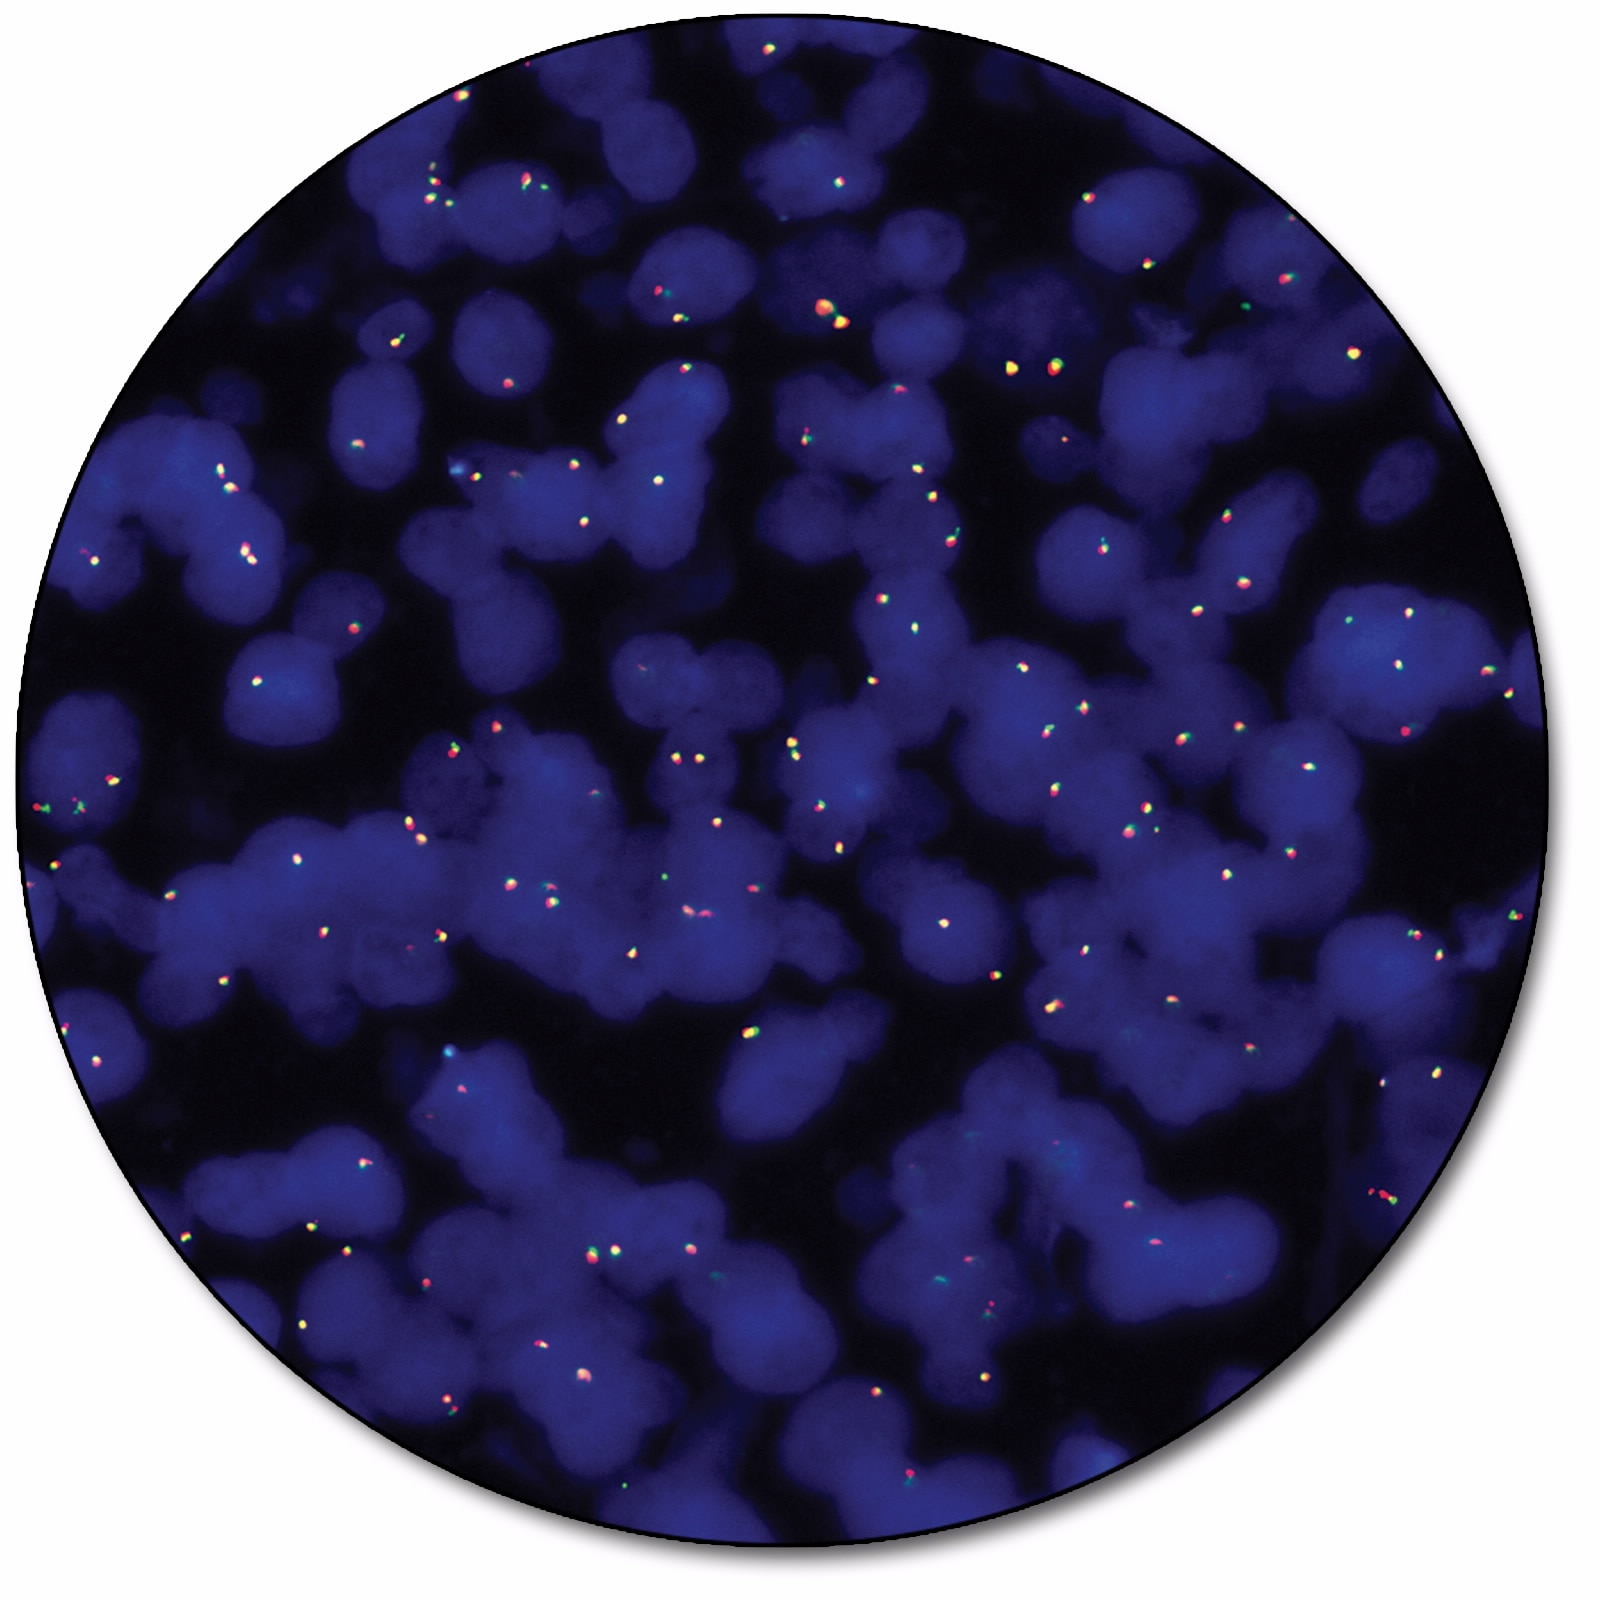

SureFISH Probes

Achieving a robust signal and minimal background, often referred to as high signal-to-noise ratio, can be one of the main challenges that is encountered when implementing a FISH assay. Using in silico design methods to eliminate repetitive elements ensure that our chemically synthesized SureFISH probes offer our customers the highest quality. To ensure that every SureFISH probe is truly repeat-free and will produce clean signal, each oligo is sequence-compared to the entire human genome to verify target specificity. All nonspecific sequences are removed. Thus, SureFISH probes eliminate the need for blocking and the signal suppression produced by blocking agents.
Use the filters in the table below to find the SureFISH probes you need.